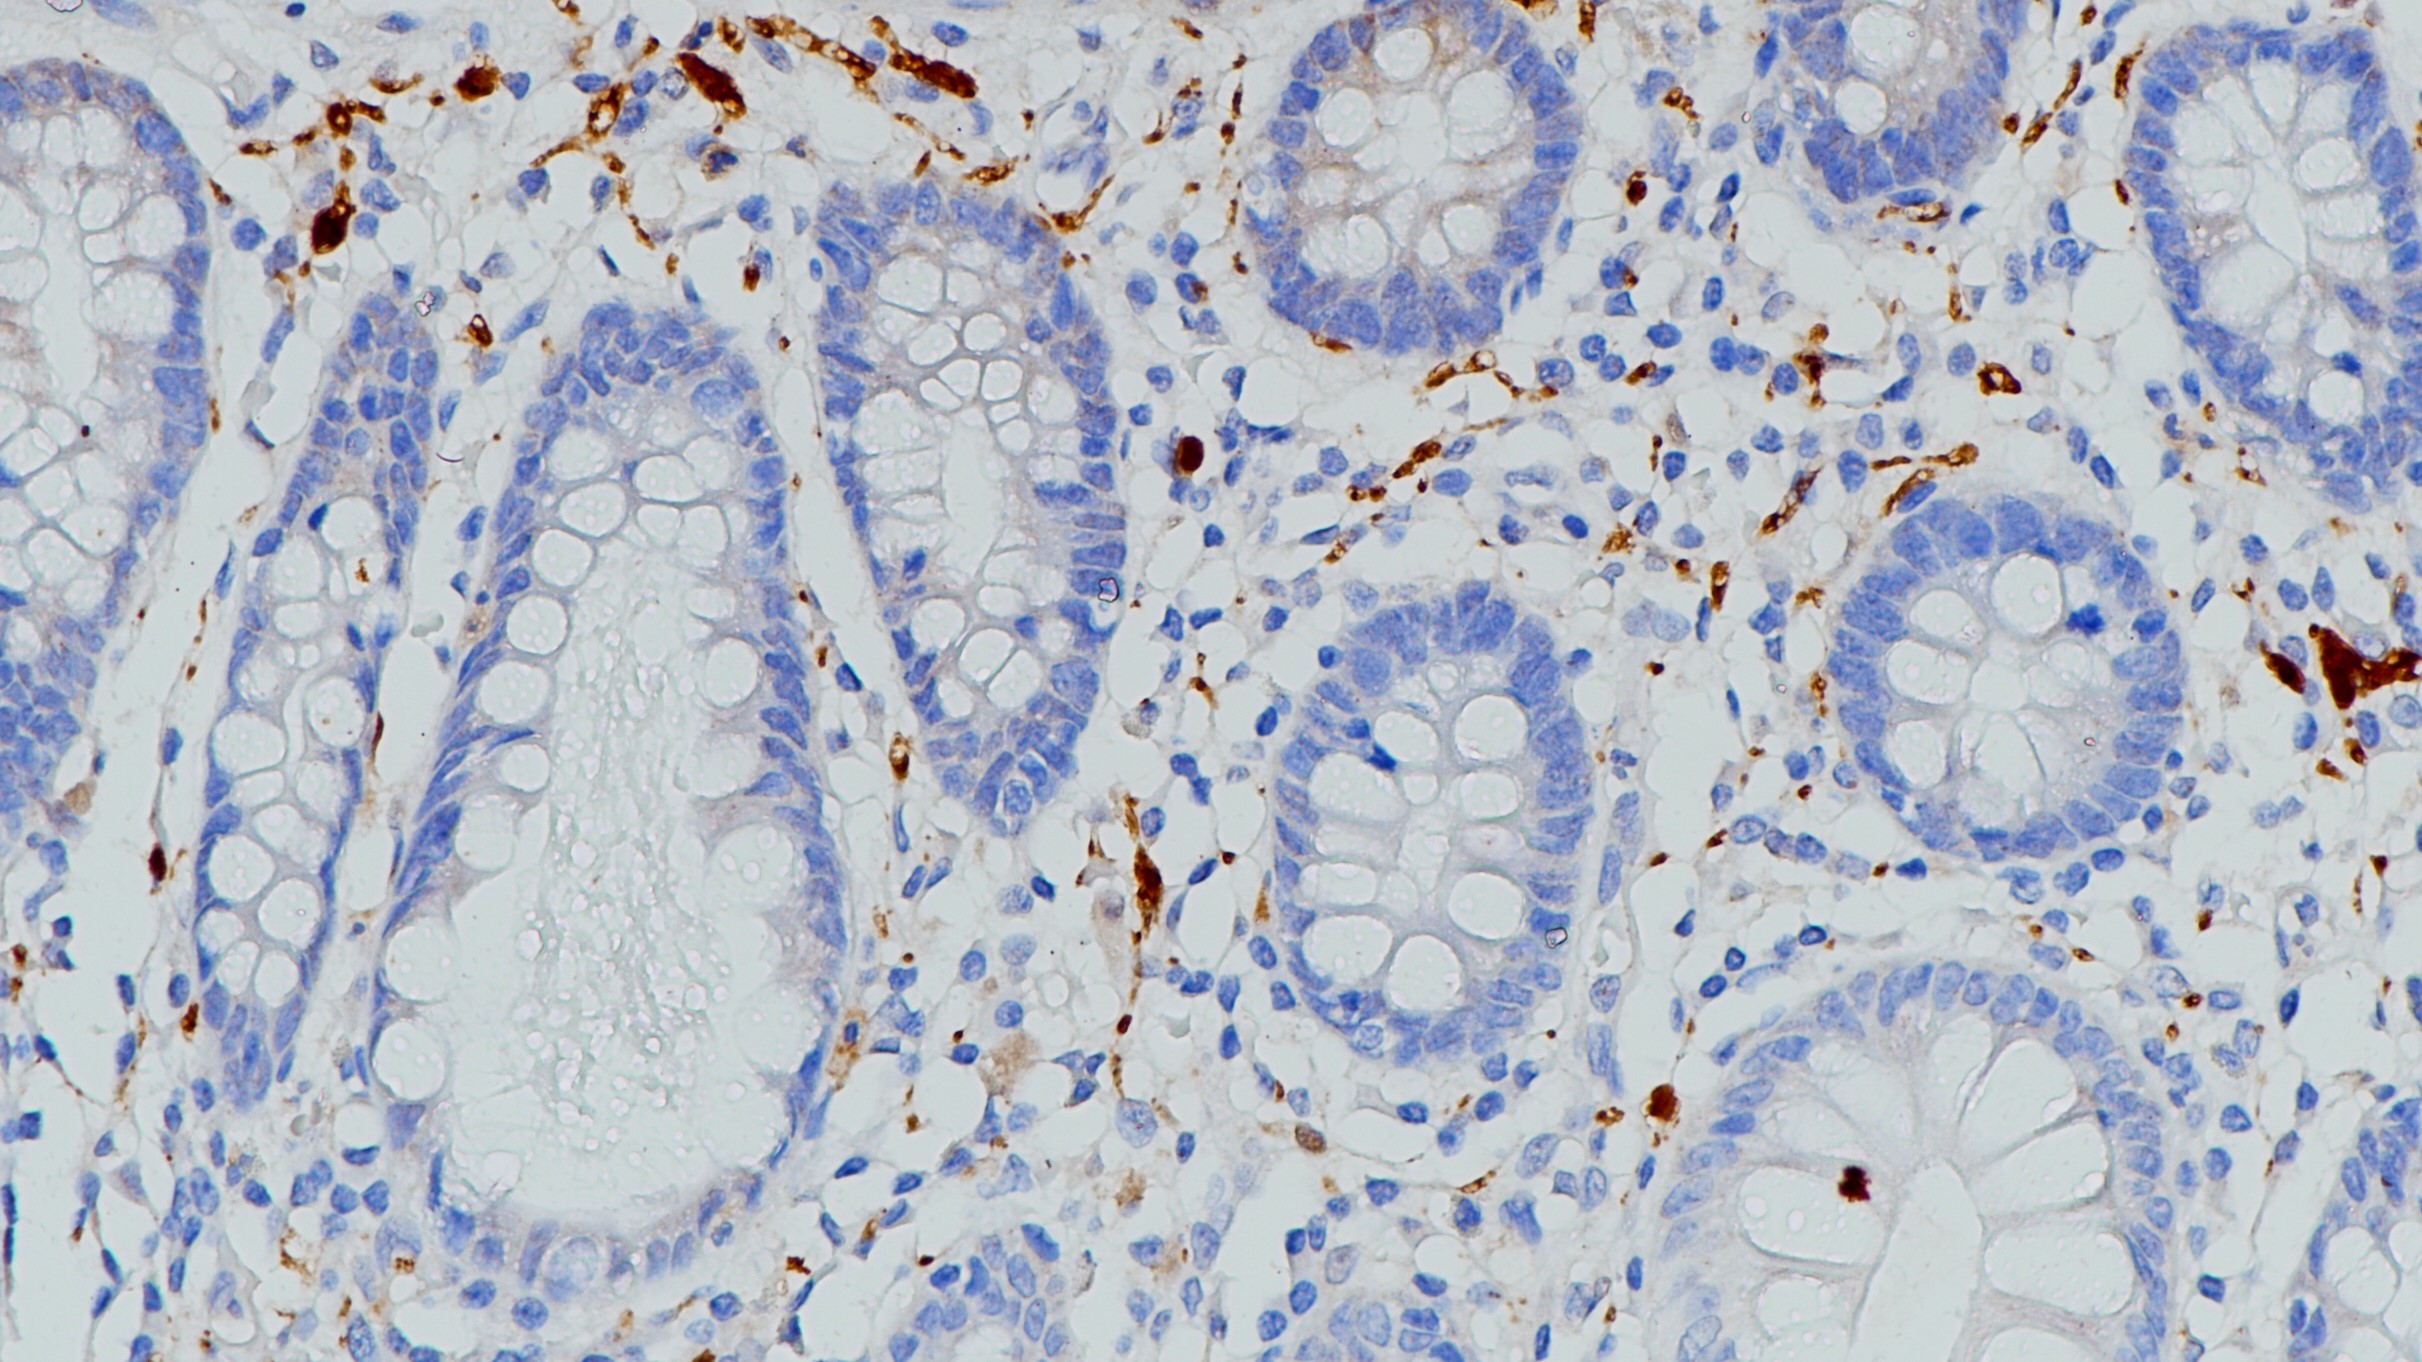
结肠S100(BP6088)染色

1. Emberley E D , Murphy L C , Watson P H . S100 proteins and their influence on pro-survival pathways in cancer.[J]. Biochemistry & Cell Biology-biochimie Et BiologieCellulaire, 2004, 82(4):508-515.
2. HarpioR ,Einarsson R . S100 proteins as cancer biomarkers with focus on S100B in malignant melanoma[J]. Clinical Biochemistry, 2004, 37(7):512-518.
3.中华医学会.《临床技术操作规范·病理学分册》.人民军医出版社,2004.